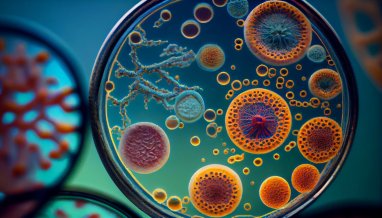

К числу необычных музеев мира, несомненно, можно отнести токийский музей паразитологии, благодаря своей уникальности ставший довольно популярной достопримечательностью Страны восходящего солнца. По мнению автора публикации в журнале «Культурология», этот музей может побить все мыслимые рекорды по количеству неприятных впечатлений от просмотра самых омерзительных паразитов, существующих в живой природе вообще и способных находиться в человеческом организме, в частности.
По сути, музей паразитологии – это ни что иное, как небольшой научно-исследовательский центр, который занимается изучением самых разных паразитов. Интерес к данной проблеме обусловлен тем фактом, что японцы постоянно принимают в пищу сырую рыбу, в которой и могут сохраняться многочисленные паразиты или их личинки.
Цель создания неординарной экспозиции, основанной доктором медицинских наук Сатору Камегай ещё в 1953 году, состоит не в получении прибыли, а в предупреждении людей об опасности, которую несут с собой в организм паразиты. Именно поэтому посещение музея паразитологии, в котором представлено порядка 45 тысяч самых разных червей и ещё около 300 других паразитов, бесплатно для всех без исключения посетителей.

Фото: kulturologia.ru/www.trover.com
На входе в музей посетителей встречает табличка с правилами поведения. В общем-то, они стандартны для всех музеев, однако с учётом специфики данного учреждения предупреждение не есть и не пить в залах, вызывает удивление. Вряд ли кому-то захочется, даже после окончания экскурсии по музею, отправиться подкрепиться в ближайшее кафе.
По всей видимости, чтобы не шокировать пытливого посетителя с порога, на первом этаже предлагается начальное знакомство с наукой паразитологией и самыми разнообразными видами паразитов. Основное место в экспозиции занимают карты, на которых наглядно показано, в каком регионе есть опасность заражения тем или иным видом паразитов. И, конечно же, вокруг просто великое множество самых разных паразитов, начиная с банальных клещей и заканчивая огромными глистами. Все они стоят в специальных колбах в заспиртованном виде. На отдельных интерактивных стендах можно увидеть схемы с полной информацией о нежелательных «соседях» рыб, животных и птиц.
Второй этаж музея имеет уже более узкую специализацию. И экспонаты здесь вызывают далеко не положительные эмоции. Все виды паразитов, которые могут жить в человеке или животном можно увидеть в самых ужасающих подробностях.
На стенде «Важные паразиты человека» можно наглядно увидеть в каких органах какие виды паразитов могут завестись. А рядом увидеть экспонаты и фотографии, изображающие последствия размножения паразитов в различных органах людей и животных. К примеру, посетителей поражает своими размерами огромный ленточный червь. Этот гигантский червь длиной 8.8 метра вышел из вполне нормального молодого японца. Для наглядности рядом со стендом, где располагается этот чудо-экспонат, висит верёвка точно такого же размера, которую можно развернуть и попытаться ответить на вопрос, как такое чудище могло вырасти в человеке всего за три месяца.
Рядом находится множество наглядных пособий, демонстрирующих, какими путями паразиты могут попасть в организм человека, и как происходит их круговорот в природе.

Фото: kulturologia.ru/www.fishki.net (Ленточный червь длиной 8,8 метра)
Трудно себе представить, что кто-то станет носить футболку с изображением жутких паразитов. Однако сувенирная лавка, работающая при Музее паразитологии, никогда не пустует. Все эти невообразимые футболки с реалистичными червями, открытки с глистами и другими паразитами, сумки для ланча с изображением всякой нечисти, поселяющейся в организме, пользуются спросом у туристов. Как и небольшие брелоки и подвески для мобильных телефонов, внутри которых находятся самые настоящие заспиртованные паразиты. Правда, некоторые особо впечатлительные гости отправляются после посещения музея прямиком в аптеку, за противопаразитными средствами.
Примечательно, для того чтобы собрать эту необычную коллекцию сотрудникам Музея понадобилось больше полувека, отмечается в источнике.
Источники: kulturologia.ru
Читайте также: